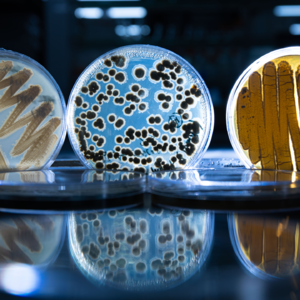
Album

主播
节目简介
来源:小宇宙
本期嘉宾:张骊駻 西湖大学天然产物化学生物学实验室 特聘研究员
本期主持:沈 是
大自然是最伟大的化学家,没有之一。人类的工作,无非是研究它,模仿它,也许,在某些方面,能偶尔超越它,谁知道呢?
这位38亿年的地球“老”化学家如同“魔法师”,她最重要的“魔杖”,无疑是——酶。“老”化学家有些歧义,显得化学好像已经陈旧,应该叫化学“老”家,亿万年来,大自然的化学既亘古不变,又常读常新。
要命的是,“魔杖”们在一起相互配合,宛若巨大化工厂——酶复合体。今天,我们要隆重介绍出其中一位明星——聚酮合酶。
这次,基于对聚酮合酶的长期研究,西湖大学张骊駻团队发展了装配线式聚酮合酶的理性重编技术。4月18日,张骊駻团队在Nature Chemical Biology《自然-化学生物学》期刊上发表两篇背靠背论文。
未来,我们可以让不同的酶来组合制造出人类需要的化学分子,一座由酶组成的“物质工厂”正在搭建中,不需要插电。
——时间轴——
00:00 节目精选
02:14 细菌:化学加工“超能力”
06:40 酶:大自然的化学“魔杖”
13:59 为什么要向细菌学习化学?
22:17 如何操控酶的基本原理?
27:07 为什么酶被改造后容易“失效”?
30:25 装配线式聚酮合酶的理性重编技术
37:46 技术展望
41:09 AI与酶的人工设计
44:51 芳香聚酮类化合物全景图
49:52 抗生素军备竞赛
52:21 嘉宾推荐:《你想活出怎样的人生》
本期主持:沈 是
大自然是最伟大的化学家,没有之一。人类的工作,无非是研究它,模仿它,也许,在某些方面,能偶尔超越它,谁知道呢?
这位38亿年的地球“老”化学家如同“魔法师”,她最重要的“魔杖”,无疑是——酶。“老”化学家有些歧义,显得化学好像已经陈旧,应该叫化学“老”家,亿万年来,大自然的化学既亘古不变,又常读常新。
要命的是,“魔杖”们在一起相互配合,宛若巨大化工厂——酶复合体。今天,我们要隆重介绍出其中一位明星——聚酮合酶。
这次,基于对聚酮合酶的长期研究,西湖大学张骊駻团队发展了装配线式聚酮合酶的理性重编技术。4月18日,张骊駻团队在Nature Chemical Biology《自然-化学生物学》期刊上发表两篇背靠背论文。
未来,我们可以让不同的酶来组合制造出人类需要的化学分子,一座由酶组成的“物质工厂”正在搭建中,不需要插电。
——时间轴——
00:00 节目精选
02:14 细菌:化学加工“超能力”
06:40 酶:大自然的化学“魔杖”
13:59 为什么要向细菌学习化学?
22:17 如何操控酶的基本原理?
27:07 为什么酶被改造后容易“失效”?
30:25 装配线式聚酮合酶的理性重编技术
37:46 技术展望
41:09 AI与酶的人工设计
44:51 芳香聚酮类化合物全景图
49:52 抗生素军备竞赛
52:21 嘉宾推荐:《你想活出怎样的人生》


